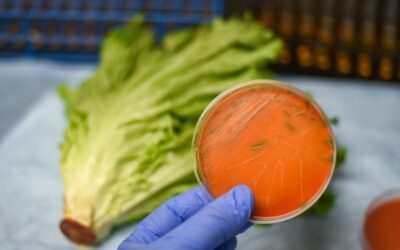
Nuevo Reglamento UE 2024/2895: Más control sobre Listeria en alimentos

📢 ¿Tu empresa usa envases en contacto con alimentos? Debes conocer El Reglamento UE 2024/3190 sobre Bisfenol A El Bisfenol A (BPA), un compuesto químico ampliamente utilizado en envases alimentarios, ha sido objeto de intensos debates debido a sus riesgos para la...
Legislación alimentaria
Nueva normativa de calidad de la miel: más transparencia para el consumidor
El Gobierno ha aprobado recientemente una modificación en la normativa de calidad de la miel, con el objetivo de ofrecer una mayor transparencia al consumidor y fortalecer la posición de la miel de origen español en el mercado. Esta actualización, alineada con las...
Nuevo Reglamento UE 2024/2895: Más control sobre Listeria en alimentos
La Comisión Europea ha aprobado el Reglamento (UE) 2024/2895, que modifica el Reglamento (CE) 2073/2005 en lo que respecta a los criterios de seguridad alimentaria para Listeria monocytogenes. El Nuevo Reglamento UE 2024/2895 establece más control sobre Listeria en...
Todo sobre el Registro Sanitario de Empresas Alimentarias
El Registro General Sanitario de Empresas Alimentarias y Alimentos (RGSEAA) es un pilar fundamental para las empresas alimentarias que operan en España. Este registro, gestionado por la Agencia Española de Seguridad Alimentaria y Nutrición (AESAN), no solo garantiza...
Cambios de los Límites de Níquel en Alimentos: Nuevo Reglamento (UE) 2024/1987
El pasado 31 de julio de 2024, se publicó el Reglamento (UE) 2024/1987 de la Comisión, de 30 de julio de 2024 , por el que se modifica el Reglamento (UE) 2023/915 en lo que respeta a los límites máximos de níquel en determinados productos alimenticios. Esta...
Se Autoriza el Uso de Maíz GM: Impacto y Regulación en la UE
La Comisión Europea ha dado un paso significativo al autorizar el uso de maíz modificado genéticamente (GM) para la alimentación humana y animal. Esta decisión, anunciada el martes 2 de julio, permite la importación de estos maíces, pero no su cultivo dentro de la...
Cómo obtener el Registro General Sanitario de Empresas Alimentarias en Madrid
La obtención del Registro General Sanitario de Empresas Alimentarias y Alimentos (RGSEAA) es un paso esencial para cualquier empresa que opere en el sector alimentario en Madrid. Este registro, establecido bajo el Reglamento 852/2004 del Parlamento Europeo y del...